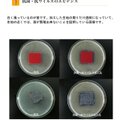

携帯用スプレーホルダー 【抗菌 抗ウイルス 倉敷帆布 岡山デニム 消毒用アルコール 】
携帯用スプレーホルダー 【抗菌 抗ウイルス 倉敷帆布 岡山デニム 消毒用アルコール 】
※ベージュが売り切れました。ブラックのみの販売になります。
消毒用アルコールなどの携帯に便利なスプレーホルダーです。
付属のフックで鞄の持ち手等に付ける事が出来るので
ほしいときにシュッとしやすく探すことなく使用できます。
倉敷帆布で出来たベージュ、岡山デニムで出来たブラックの2色ご用意しました。
50mlまでのスプレーが入ります。
※スプレーは付属しておりません。
抗菌・抗ウイルス加工のデニムと帆布で出来ています。
洗濯しても抗菌・抗ウイルスの効果が持続するので
安心して衛生的にご使用出来ます。
通常のデニム生地より色の落ちにくい染め方をしているので、
手や、バッグ内にも色が移りにくくなっています。
<使用素材>
倉敷帆布 綿100%
岡山デニム 綿100%
<カラー>
ブラック
ベージュ
<サイズ>
縦10cm、横7.5cm(口径5.5cm)
紐の長さ20cm
購入の際の注意点
・商品のお色はお客様のPC環境によって多少色合い、見え方など違ってまいりますのでご了承下さいますようお願いします。
・色の薄い素材のものとの摩擦などで色移りが起こる場合があります。
送料、配送
・クリックポストでお届けいたします
・お買い上げ金額が合計5000円未満の場合、送料は一律198円です
・ポスト投函となりますので、日時指定を承ることができません。通常、発送後1〜3日で到着しますが、配送状況によっては遅れる可能性がある事をご了承下さい
発送方法
発送までの目安
ご購入の際の注意点
・色の薄い素材のものとの摩擦などで色移りが起こる場合があります。
ショップへの感想コメント
(54)-
とても素敵な作品で期待通りです。 ありがとうございました。
-
スムーズなお取り引きで、商品も無事に届きました。 実物も素敵で、プレゼントする友人も喜んでくれると思います。 どうもありがとうございました。
-
カーキと赤を購入、両方とも素敵な色です。 大きさ、形も可愛くて、化粧品や、鍵や小物入れにと革の色合い変化を楽しみながら使っていきます。